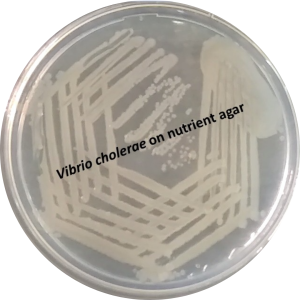

MORPHOLOGY & VIRULENCE
Morphology of Vibrio cholera
What is morphology?
The morphology of a bacteria or microorganism refers to the shape, size and external characteristics or structures of the microorganism. To determine the morphology of a microorganism one can use various staining methods and microscopy. For example scientists can determine whether a bacteria is spherical (cocci), rod-like (bacillus) or spiral in shape.
Morphology of Vibrio cholerae
Link to Taxonomy
Vibrio cholerae’s morphology is linked to its name or taxonomy. The genus Vibrio is derived from the family Vibrionaceae, pathogenic microorganisms found in aquatic environments. Therefore, Vibrio cholerae is commonly known as a waterborne bacteria. Pathogenic organisms carry traits that cause sickness and diseases in humans and/or animals. The word Vibrio also refers to the spiral shape of a single bacterial cell, as it looks like a comma when viewed under a microscope.
Clues within the stain: cell wall morphology
Scientists use various staining methods to prepare certain characteristics of microorganisms for microscopic examination. Certain stains highlight external structures such as flagella, which is the tail of the bacteria. But did you know the colour of these stains also holds valuable information?
A cell wall is present in bacteria to give rigidity and shape to the cell due to turgor pressure. It can be seen informally as a thick or thin brick layer surrounding a house (in this case, the cell).
Gram staining can be used to determine the morphology of this cell wall. During a Gram stain, a bacterial smear is first flooded with a primary stain, Crystal violet, which stains the bacterial cell wall purple-blue. Followed by flooding with iodine, used as a mordant, which aids in sticking the Crystal Violet to the cell wall. Gram-negative bacteria have a thin peptidoglycan layer (part of the cell wall), whereas Gram-positive bacteria have a thick peptidoglycan layer in their cell wall.
Therefore, alcohol is used as a differential medium during Gram staining as it decolorizes Gram-negative bacteria’s thin peptidoglycan layer within the cell wall. As Gram-positive bacteria’s cell-wall retains the primary stain, it will remain blue-purple in colour. To enhance the viewing of Gram-Negative bacteria, a counterstain, usually Saffrin, which is pink in colour, is used.
In other words, a Gram-Positive bacteria will have a purple-blue stain, and Gram-negative bacteria will have a pink colour stain.
Therefore it is possible to determine the cell-wall morphology of Vibrio cholerae after a Gram-stain. Vibrio cholera has a pink gram stain colour, indicating that it is a Gram-negative bacteria. What does this mean with regards to morphology? Gram-Negative bacteria has a tick cell-wall consisting of two main layers: Peptidoglycan and an outer membrane . The peptidoglycan only counts towards 10% of the cell wall and is therefore thin. The outer membrane consists of lipopolysaccharides (LPS) and proteins.
Knowing the cell wall morphology of Vibrio cholerae is advantageous as it aids in identifying the correct clinical treatment and determining the microbial causes of Cholera. The outermembrane has components called Lipopolysaccharides (LPS), which is usually toxic and can cause an immune response in its host, making Vibrio cholerae pathogenic. Vibrio cholerae is also resistant to some antibiotics like penicillin due to its thick outer membrane.
3D Model of the Morphology of Vibrio cholerae
Beyond the cell wall
Flagella
There are often external structures present in bacteria such as flagella and pili. Flagella in simple terms is the tail of the bacteria that is responsible for moving the bacteria. There are two major types of flagellum namely polar flagella used for swimming in aquatic environments and lateral flagella for swarming on non-liquid surfaces. Vibrio cholera has a singular polar flagellum (monotrichous), which consists of a basal body, hook and filament. This tail, or flagellum, isn’t flexible but rather rigid and can be seen as a propeller, like the propeller of a boat. The flagellum moves anticlockwise while the bacteria moves clockwise, resulting in a forward movement of the bacteria.
Fimbriae and pili
Apart from the flagella, other external structures are also present on the outside layer of the bacteria that aids in moving. Fimbriae and pili are found on the cell wall and have a hair-like structure. Fimbriae are responsible for attaching the bacteria to surfaces whereas pili link onto pili of nearby bacteria to transfer DNA (genetic material). More information regarding the role of fimbriae and pili can be found in the virulence section.
Glycocalyx
The glycocalyx is a slime layer or capsule covering the outside of the bacteria for protection against phagocytosis as a result of the host’s immune response. Phagocytosis occurs when the host’s immune system detects the pathogenic bacteria and kills it. The glycocalyx can be organized and bound to the cell wall, forming a capsule, or it can be loosely attached forming a slime layer. When more than one Vibrio cholerae attaches to a surface, biofilm formation starts. Vibrio cholerae produces a sticky liquid made up of biofilm-associated extracellular polysaccharide (EPS) that helps it to attachment to surfaces and nearby cells. This ensures Vibrio cholerae can colonize and communicate (Quorum Sensing) within the biofilm matrix (sticky liquid) while protected from being attacked by immune cells of the host (phagocytosis).
In morphology, this is important to note because the biofilm layer can resist clinical treatments and external environmental stressors.
Internal Morphology
As bacteria such as Vibrio cholerae,fall under prokaryotic cells, it does not have membrane bound organelles.Think of organelles as tiny organs found within a cell, each has a unique role that works together for the cell to live. In cells these “organs” can be organized in compartments (eukaryotic bacteria) or without compartments (prokaryotic bacteria). Instead bacteria have intracellular components located loosely within the cytoplasm (liquid medium). The full genetic make up of Vibrio cholerae consists of one bacterial chromosome found within the nucleoid. Other than the DNA found in the nucleoid, there is also DNA within plasmids.This DNA can replicate on its own and is crucial for the survival of bacteria when faced with unfavourable environments.
Ribosomes are also found within the cytoplasm and it is responsible for making proteins. These proteins are the building blocks for all the cell’s components and activities. Certain medications can inhibit ribosomes and the production of proteins to stop infections. Within the cytoplasm there are also inclusion bodies which store phosphate for survival. A study published in the FEMS Microbiology Letters found that these inclusion bodies are diminished when Vibrio cholerae are placed in an unfavourable environment. Indicating that the cell uses the stored nutrients when placed under stress.
In short, think of a cell as a big factory: The building is the cell wall, within the building there are various systems and components. The computer that holds the design and information of the product that is being made, is the nucleoid. A smaller computer might be present that holds information about accessory products that can be made to enhance the main product – this is the plasmids. The machines that make the products and indicate if they should be transported for delivery or stay in the factory, are the ribosomes. The storage unit for the materials of this product is the inclusion bodies.
It is also important to note that certain bacteria contain endospores: a unique structure that encapsulates the bacterial cell during inhabitable conditions in order to survive. Vibrio cholerae does not form endospores.
Colony Morphology
Colony morphology refers to the shape, size, and appearance of bacteria when it is grown on medium such as agar plates. The incubation conditions of the agar plates should also be taken in consideration: certain bacteria can not live in the presence of oxygen (obligate anaerobes) or require high temperatures to grow (thermophiles). This method is useful to identify and differentiate between microorganisms and their living conditions.
The Thiosulfate-Citrate-Bile Salts-Sucrose (TCBS) agar is primarily used to identify and grow Vibrio cholerae. It contains bile salts and has a high pH, which can stop the growth of other organisms but increases the growth of Vibrio Cholerae. A yellow halo can be seen around the colonies of Vibrio cholerae as it ferments sucrose, causing the color to change.
On Nutrient Agar, which is a basic agar plate with no added substances, the colonies can be described as smooth, creamy coloured, large, round, and convex.
The growing conditions of Vibrio Cholerae include an optimum temperature of 37 °C, equivalent to the human body temperature. It is also a facultative anaerobe, meaning it can grow in the presence or absence of Oxygen.
Virulence of Vibrio cholerae
Virulence refers to the traits of a microorganism that causes harm to its host. Vibrio cholerae has a few virulence traits that causes infections in the human intestine, leading to Cholera.
Cholera Toxin
The main cause of Cholera is due to the release of an enterotoxin, Cholera Toxin. It is made up of two components that have their own individual function. Component B assists in attaching to human cells (enterocytes) in the human intestine. Whereas Component A enters the cell and takes over the communication system of the cell. G-proteins in the human cell, which act as messengers, are then activated full-time, causing continuous messages in the cell.
The increase in messages leads to the activation of other messengers and systems: adenylate cyclase are switched on which in return activates cAMP. Therefore when the cAMP levels rise in the cell, a channel in the cell wall , called the cAMP- regulated chloride channel (CFTR), opens and the cell pushes out chloride. Due to the concentration imbalance within the cell, sodium is not entering the cell. Consequently water pushes out of the cell due to osmosis, and into the intestine. This leads to diarrhea, the leading symptom of Cholera. For a more detailed version of the effects of the Cholera Toxin please read here.
Pili Virulence in Vibrio cholerae
Type IV pili (hair-like structures outside the cell) plays a significant role in pathogenicity and virulence as it is part of moving, biofilm formation and colonisation in bacteria. In Vibrio cholera the Type IV pili is called Vibrio cholera Toxin-Coregulated Pilus (TCP) and it works concurrently with the major virulence factor, Cholera Toxin, during host colonization.This pili causes nearby cells to come together in the small intestine of the human body, leading to a concentration of the cholera toxin.
Outer Membrane Vesicles (OMVs)
Outer Membrane Vesicles in simple terms are small transport molecules that are formed in Gram Negative bacteria. The formation of these vesicles occur when a section of the peptidoglycan layer of the cell wall bulges out and detaches from the cell wall. But what is so significant about these vesicles?
In Vibrio cholerae the outer membrane vesicles transport the Cholera toxin to distant host cells in the intestine. The vesicles also assists in protecting the main virulence factor, in order for it to continue under a stressed environment such as encounters with enzymes, cells that breaks down food in the intestine (intestinal proteases). Therefore Cholera toxin remains in the human gut even after the bacteria Vibrio cholerae has left. This causes higher and prolonged levels of dehydration and diarrhea.
Quorum sensing
Bacteria has a special communication system called quorum sensing. As previously mentioned it is important during biofilm formation with nearby cells for protection. But this communication is also a virulence factor as cells communicate and have different gene expression based on the cell density of the bacteria. In short, Vibrio cholerae releases autoinducers, as the colony grows in the intestine the levels of autoinducers grows as well. Higher autoinducers levels act as an indicator for the bacteria to attack, signalling that the colony is big enough to make an impact on the host. Then, through quorum sensing Vibrio cholerae starts to release the primary virulence factor, Cholera toxin. This is also the method Vibrio cholerae uses to leave the host, in order to infect a new one. Through quorum sensing the bacteria “decides” to detach from the human cells (enterocytes) in the intestine and leaves the host through fecal shedding.
Conclusion
Understanding and examining the morphology of Vibrio cholerae is an essential part of determining how to treat and prevent Cholera. Through this knowledge one can identify and examine the virulence factors of Vibrio cholerae to assist in the production of vaccination and medication for Cholera.
References:
https://www.sciencedirect.com/topics/medicine-and-dentistry/vibrionaceae https://pmc.ncbi.nlm.nih.gov/articles/PMC2238685/#R10
https://pmc.ncbi.nlm.nih.gov/articles/PMC3089049/
https://pmc.ncbi.nlm.nih.gov/articles/PMC2238685/#R10
https://www.frontiersin.org/journals/microbiology/articles/10.3389/fmicb.2022.1029146/full
https://pubmed.ncbi.nlm.nih.gov/34076466/
https://emedicine.medscape.com/article/962643-overview#a4
https://pmc.ncbi.nlm.nih.gov/articles/PMC10196187/
https://pmc.ncbi.nlm.nih.gov/articles/PMC93596/
https://www.nature.com/articles/ncomms5913
https://journals.asm.org/doi/epdf/10.1128/iai.14.2.527-547.1976
https://www.annualreviews.org/content/journals/10.1146/annurev-micro-040621-122027
https://www.sciencedirect.com/topics/immunology-and-microbiology/endospore
https://academic.oup.com/femsle/article-abstract/180/2/123/525404
https://universe84a.com/collection/vibrio-cholerae-nutrient-agar/